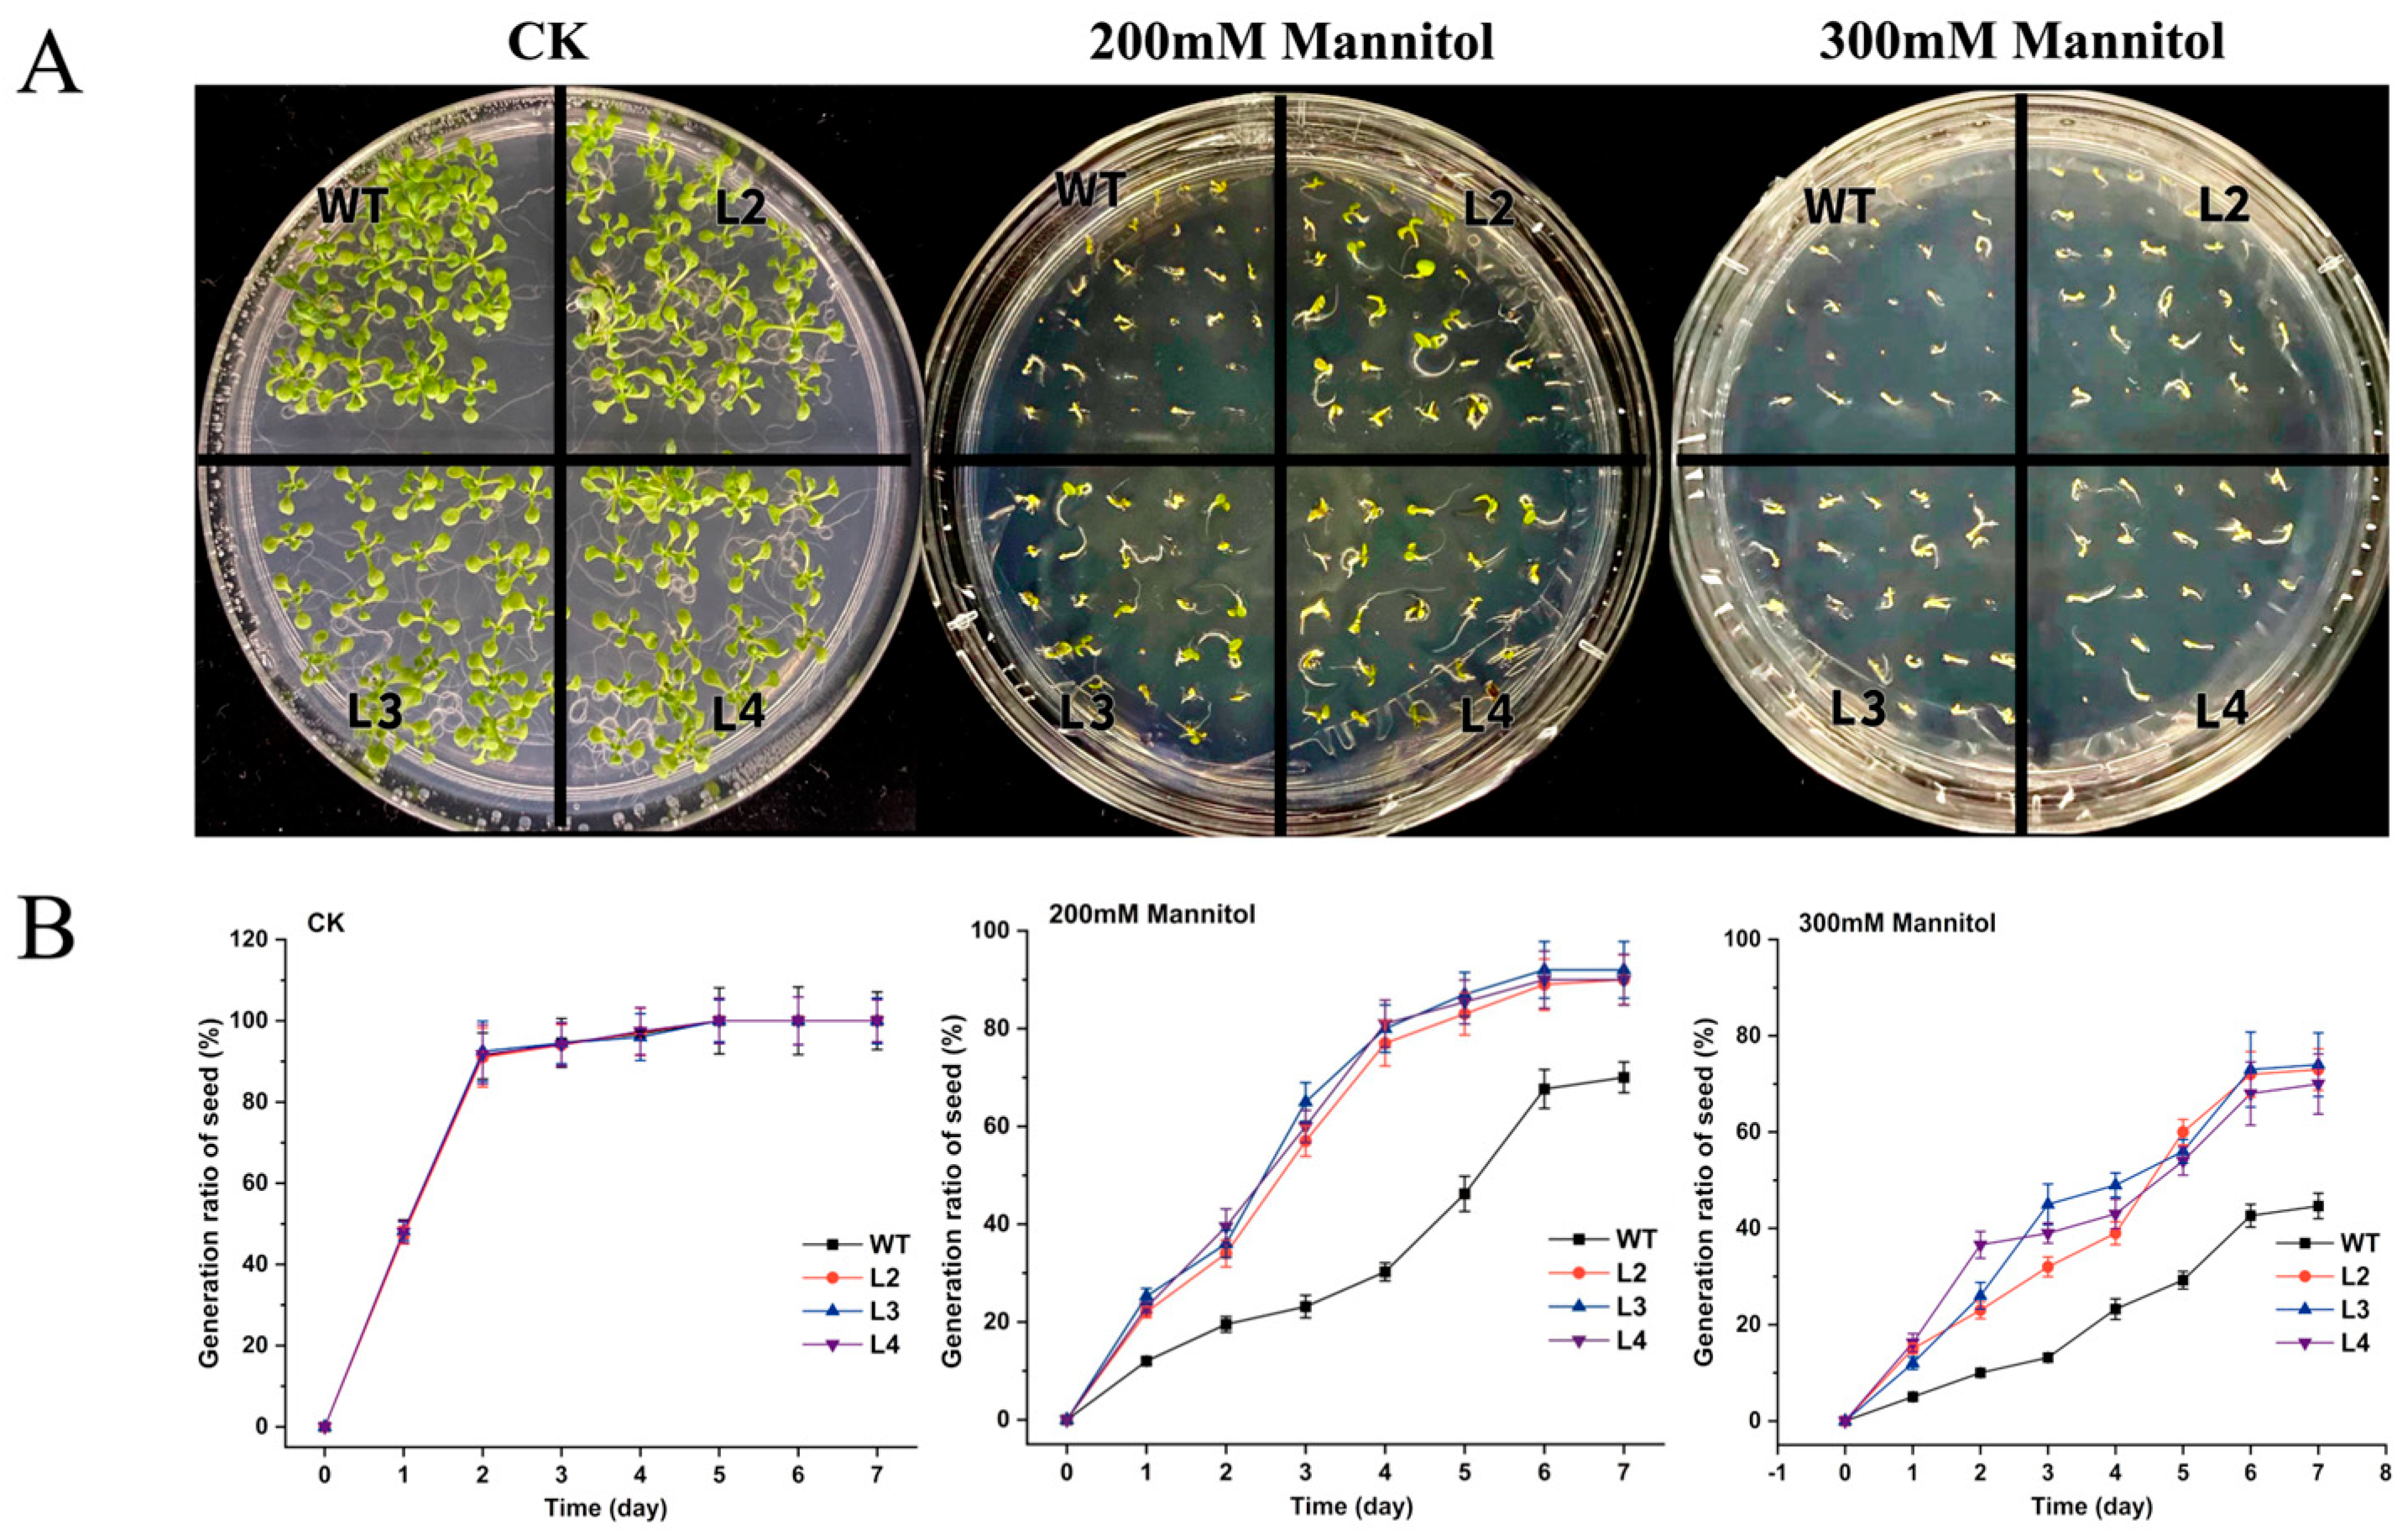
Forests 15 01988 g006 Forests 15 01988 g006

Identification of Picea mongolica LEA Gene Family Implicates PmLEA25 in Drought Resistance
Abstract
1. Introduction
2. Materials and Methods
2.1. Plant Materials and Drought Stress Treatment
2.2. Identification of PmLEAs and Sequence Analysis
2.3. Phylogenetic and Evolutionary Tree Construction
2.4. Expression Analysis of PmLEAs
2.5. Characterization of Cis-Elements in Promoter Region of PmLEA25
2.6. Construction of PmLEA25 Overexpression Vector and Genetic Transformation of Arabidopsis thaliana
2.7. Screening of Positive Plants
2.8. Phenotypic Observation and Physiological Assays
3. Results
3.1. Identification and Phylogenetic Study of LEA Gene Family in P. mongolica
3.2. Protein Conserved Motif Analysis of LEAs in P. mongolica
3.3. Transcript Pattern of PmLEAs During Somatic Embryo Development by RNA-Seq
3.4. Expression Analysis of PmLEAs Under Drought Stress
3.5. Overexpression of PmLEA25 Enhances Drought Resistance in Transgenic Arabidopsis
4. Discussion
5. Conclusions
Supplementary Materials
Author Contributions
Funding
Data Availability Statement
Conflicts of Interest
References
- Ha, B.R.; Bai, Y.E.; Hou, W.F.; Qing, S. Research progress and prospect of Picea mongolica of species endemic to sandy land. North. Hortic. 2021, 14, 152–157. (In Chinese) [Google Scholar]
- Zou, C.J.; Han, S.J.; Xu, W.D. Formation, distribution, and nature of Picea mongolica in China. J. For. Res. 2001, 12, 187–191. [Google Scholar]
- Huang, S.X.; Li, X.B.; Lin, T.M.; Quan, C.M.; Luo, J.C.; Wang, L.X. Breeding techniques and annual growth rhythm of Picea mongolica seedlings. J. Beijing For. Univ. 2003, 25, 11–14. (In Chinese) [Google Scholar]
- Li, X.Y. Analysis on physiological and biochemical indexes of leaves of 8 Picea Plants. For. Sci. Tech. 2020, 4, 26–30. (In Chinese) [Google Scholar]
- Yan, J.; Peng, P.; Duan, G.Z.; Lin, T.; Bai, Y.E. Multiple analyses of various factors affecting the plantlet regeneration of Picea mongolica (H. Q. Wu) W.D. Xu from somatic embryos. Sci. Rep. 2021, 11, 6694. [Google Scholar] [CrossRef]
- Shi, X.; Wang, C.E.; Liu, Y.; Jiang, H.Y.; Jin, S.T. Distribution of Endophytic Fungi in Picea mongolica. J. Anhui Agric. Sci. 2016, 44, 20–22. (In Chinese) [Google Scholar]
- Latchman, D.S. Transcription Factors: An Overview. Int. J. Biochem. Cell Biol. 1997, 29, 1305–1312. [Google Scholar] [CrossRef]
- Artur, M.A.S.; Zhao, T.; Ligterink, W.; Schranz, E.; Hilhorst, H.W.M. Dissecting the Genomic Diversification of Late Embryogenesis Abundant (LEA) Protein Gene Families in Plants. Genome Biol. Evol. 2019, 11, 459–471. [Google Scholar] [CrossRef]
- Garay-Arroyo, A.; Colmener-Flores, J.M.; Garciarrubio, A.; Covarrubias, A.A. Highly hydrophilic proteins in prokaryotes and eukaryotes are common during conditions of water deficit. J. Biol. Chem. 2000, 275, 5668–5674. [Google Scholar] [CrossRef]
- Hunault, G.; Jaspard, E. LEAPdb: A database for the late embryogenesis abundant proteins. BMC Genom. 2010, 11, 221. [Google Scholar] [CrossRef]
- Dure, L.R.; Crouch, M.; Harada, J.; Ho, T.H.; Mundy, J.; Quatrano, R.; Thomas, T.; Sung, Z.R. Common amino acid sequence domains among the LEA proteins of higher plants. Plant Mol. Biol. 1989, 12, 475–486. [Google Scholar] [CrossRef] [PubMed]
- Dure, L.; Greenway, S.C.; Galau, G.A. Developmental biochemistry of cottonseed embryogenesis and germination: Changing messenger ribonucleic acid populations as shown by in vitro and in vivo protein synthesis. Biochemistry 1981, 20, 4162–4168. [Google Scholar] [CrossRef] [PubMed]
- Hundertmark, M.; Hincha, D.K. LEA (late embryogenesis abundant) proteins and their encoding genes in Arabidopsis thaliana. BMC Genom. 2008, 9, 118. [Google Scholar] [CrossRef] [PubMed]
- Wang, X.S.; Zhu, H.B.; Jin, G.L.; Liu, H.L.; Wu, W.R.; Zhu, J. Genome-scale identification and analysis of LEA genes in rice (Oryza sativa L.). Plants 2007, 172, 414–420. [Google Scholar] [CrossRef]
- Li, X.; Cao, J. Late embryogenesis abundant (LEA) gene family in Maize: Identification, evolution, and expression profiles. Plant Mol. Biol. Rep. 2016, 34, 15–28. [Google Scholar] [CrossRef]
- Cao, J.; Li, X. Identification and phylogenetic analysis of late embryogenesis abundant proteins family in tomato (Solanum lycopersicum). Planta 2015, 241, 757–772. [Google Scholar] [CrossRef]
- Cheng, Z.H.; Zhang, X.M.; Yao, W.J.; Zhao, K.; Liu, L.; Fan, G.F.; Zhou, B.; Jiang, T.B. Genome-wide search and structural and functional analyses for late embryogenesis-abundant (LEA) gene family in poplar. BMC Plant Biol. 2021, 21, 110. [Google Scholar] [CrossRef]
- Gao, J.; Lan, T. Functional characterization of the late embryogenesis abundant (LEA) protein gene family from Pinus tabuliformis (Pinaceae) in Escherichia coli. Sci. Rep. 2016, 6, 19467. [Google Scholar] [CrossRef]
- Wilhelm, K.S.; Thomashow, M.F. Arabidopsis thaliana cor15a, an apparent homologue of cor15a, is strongly responsive to cold and ABA, but not drought. Plant Mol. Biol. 1993, 23, 1073–1077. [Google Scholar] [CrossRef]
- Welin, B.V.; Olson, A.; Nylander, M.; Palva, E.T. Characterization and differential expression of dhn/lea/rab-like genes during cold acclimation and drought stress in Arabidopsis thaliana. Plant Mol. Biol. 1994, 26, 131–144. [Google Scholar] [CrossRef]
- Jia, F.J.; Qi, S.D.; Li, H.; Liu, P.; Li, P.C.; Wu, C.G.; Zheng, C.C.; Huang, J.G. Overexpression of Late Embryogenesis Abundant 14 enhances Arabidopsis salt stress tolerance. Biochem. Biophys. Res. Commun. 2014, 454, 505–511. [Google Scholar] [CrossRef] [PubMed]
- Kong, H.; Xia, W.W.; Hou, M.J.; Ruan, N.; Li, J.; Zhu, J.B. Cloning and function analysis of a Saussurea involucrata LEA4 gene. Front. Plant Sci. 2022, 13, 957133. [Google Scholar] [CrossRef] [PubMed]
- Liu, X.Y.; Xia, W.W.; Zhang, X.L.; Li, A.W.; Qin, J.W.; Sun, H.L.; Li, J.; Zhu, J.B. Overexpression of the SiLEA5 gene in Saussurea involucrata increases the Low-Temperature tolerance of transgenic tomatoes. Horticulturae 2022, 8, 1023. [Google Scholar] [CrossRef]
- Wang, Z.K.; Yang, Q.; Shao, Y.P.; Zhang, B.B.; Feng, A.Y.; Meng, F.L.; Li, W.B. GmLEA2-1, a late embryogenesis abundant protein gene isolated from soybean (Glycine max (L.) Merr.), confers tolerance to abiotic stress. Acta Biol. Hung. 2018, 69, 270–282. [Google Scholar] [CrossRef] [PubMed]
- Shen, Y.Z.; Wei, J.P.; Zhou, Y.L.; Zhu, Y.J.; Liu, S.S.; Wang, Y.L.; Ma, H. Soybean late embryogenesis abundant protein GmLEA4 interacts with GmCaM1, enhancing seed vigor in transgenic Arabidopsis under high temperature and humidity stress. Plant Growth Regul. 2022, 99, 583–595. [Google Scholar] [CrossRef]
- Bai, Y.Q.; Yang, Q.C.; Kang, J.M.; Sun, Y.; Gruber, M.; Chao, Y.H. Isolation and functional characterization of a Medicago sativa L. gene, MsLEA3-1. Mol. Biol. Rep. 2012, 39, 2883–2892. [Google Scholar] [CrossRef][Green Version]
- Jia, H.L.; Wang, X.M.; Shi, Y.H.; Wu, X.M.; Wang, Y.Q.; Liu, J.N.; Fang, Z.H.; Li, C.Y.; Dong, K.H. Overexpression of Medicago sativa LEA4-4 can improve the salt, drought, and oxidation resistance of transgenic Arabidopsis. PLoS ONE 2020, 15, e0234085. [Google Scholar] [CrossRef]
- Lv, A.M.; Su, L.T.; Wen, W.W.; Fan, N.N.; Zhou, P.; An, Y. Analysis of the function of the Alfalfa Mslea-D34 gene in abiotic stress responses and flowering time. Plant Cell Physiol. 2021, 62, 28–42. [Google Scholar] [CrossRef]
- Luo, D.; Zhang, X.; Li, Y.L.; Wu, Y.G.; Li, P.Z.; Jia, C.L.; Bao, Q.Y.; Zhou, Q.; Fu, C.X.; Liu, W.X.; et al. MsDIUP1 encoding a putative novel LEA protein positively modulates salt tolerance in alfalfa (Medicago sativa L.). Plant Soil 2023, 487, 547–566. [Google Scholar] [CrossRef]
- Zhou, M.Q.; Peng, N.F.; Yang, C.P.; Wang, C. The Poplar (Populus trichocarpa) dehydrin gene PtrDHN-3 enhances tolerance to salt stress in Arabidopsis. Plants 2022, 11, 2700. [Google Scholar] [CrossRef]
- Hall, T.A. BioEdit: A user-friendly biological sequence alignment program for Windows 95/98/NT. Nucleic Acids Symp. Ser. 1999, 41, 95–98. [Google Scholar]
- Zhang, X.; Henriques, R.; Lin, S.S.; Niu, Q.W.; Chua, N.H. Agrobacterium-mediated transformation of Arabidopsis thaliana using the floral dip method. Nat. Protoc. 2006, 1, 641–646. [Google Scholar] [CrossRef] [PubMed]
- Tunnacliffe, A.; Wise, M.J. The continuing conundrum of the LEA proteins. Naturwissenschaften 2007, 94, 791–812. [Google Scholar] [CrossRef] [PubMed]
- Bhardwaj, R.; Sharma, I.; Kanwar, M.; Sharma, R.; Handa, N.; Kaur, H.; Poonam, D.K. LEA proteins in salt stress tolerance. In Salt Stress Plants; Springer: New York, NY, USA, 2013; pp. 79–112. [Google Scholar]
- Mohanty, S.; Hembram, P. An overview of LEA genes and their importance in combating abiotic stress in Rice. Plant Mol. Biol. Rep. 2024, 1–15. [Google Scholar] [CrossRef]
- Liang, Y.; Xiong, Z.; Zheng, J.; Xu, D.; Zhu, Z.; Xiang, J.; Gan, J.; Raboanatahiry, N.; Yin, Y.; Li, M. Genome-wide identification, structural analysis and new insights into late embryogenesis abundant (LEA) gene family formation pattern in Brassica napus. Sci. Rep. 2016, 6, 24265. [Google Scholar] [CrossRef]
- İbrahime, M.; Kibar, U.; Kazan, K.; Özmen, C.Y.; Mutaf, F.; Aşçı, S.D.; Aydemir, B.C.; Ergül, A. Genome-wide identification of the LEA protein gene family in grapevine (Vitis vinifera L.). Tree Genet. Genomes 2019, 15, 55. [Google Scholar] [CrossRef]
- Jia, C.; Guo, B.; Wang, B.; Li, X.; Yang, T.; Li, N.; Wang, J.; Yu, Q. The LEA gene family in tomato and its wild relatives: Genome-wide identification, structural characterization, expression profiling, and role of SlLEA6 in drought stress. BMC Plant Biol. 2022, 22, 596. [Google Scholar] [CrossRef]
- Huang, R.L.; Xiao, D.; Wang, X.; Zhan, J.; Wang, A.Q.; He, L.F. Genome-wide identification, evolutionary and expression analyses of LEA gene family in peanut (Arachis hypogaea L.). BMC Plant Biol. 2022, 22, 155. [Google Scholar] [CrossRef]
- Jin, X.; Cao, D.; Wang, Z.; Ma, L.; Tian, K.; Liu, Y.; Gong, Z.; Zhu, X.; Jiang, C.; Li, Y. Genome-wide identification and expression analyses of the LEA protein gene family in tea plant reveal their involvement in seed development and abiotic stress responses. Sci. Rep. 2019, 9, 14123. [Google Scholar] [CrossRef]
- Yu, X.M.; Yue, W.R.; Yang, Q.; Zhang, Y.N.; Han, X.M.; Yang, F.Y.; Wang, R.G.; Li, G.J. Identification of the LEA family members from Caragana korshinskii (Fabaceae) and functional characterization of CkLEA2-3 in response to abiotic stress in Arabidopsis. Braz. J. Bot. 2019, 42, 227–238. [Google Scholar] [CrossRef]
- Li, L.; Xu, H.L.; Yang, X.L.; Li, Y.X.; Hu, Y.K. Genome-wide identification, classification and expression analysis of LEA gene family in Soybean. Sci. Agric. Sin. 2011, 44, 3945–3954. (In Chinese) [Google Scholar]
- Li, J.; Zhao, A.C.; Wang, X.L.; Liu, X.Q.; Yu, M.D. On genome-scale identification and expression onanalysis of LEA gene in Poplar. J. South China Norm. Univ. 2016, 41, 48–56. (In Chinese) [Google Scholar]
- Wang, W.D.; Gao, T.; Chen, J.F.; Yang, J.K.; Huang, H.Y.; Yu, Y.B. The late embryogenesis abundant gene family in tea plant (Camellia sinensis): Genome-wide characterization and expression analysis in response to cold and dehydration stress. Plant Physiol. Bioch. 2019, 135, 277–286. [Google Scholar] [CrossRef] [PubMed]
- Goldberg, R.B.; Barker, S.J.; Perez-Grau, L. Regulation of gene expression during plant embryogenesis. Cell 1989, 56, 149–160. [Google Scholar] [CrossRef] [PubMed]
- Zan, T.; Li, L.Q.; Li, J.T.; Zhang, L.; Li, X.J. Genome-wide identification and characterization of late embryogenesis abundant protein-encoding gene family in wheat: Evolution and expression profiles during development and stress. Gene 2020, 736, 144422. [Google Scholar] [CrossRef]
- Liu, Y.; Wang, L.; Xing, X.; Sun, L.; Pan, J.; Kong, X.; Zhang, M.; Li, D. ZmLEA3, a multifunctional group 3 LEA protein from maize (Zea mays L.), is involved in biotic and abiotic stresses. Plant Cell Physiol. 2013, 54, 944–959. [Google Scholar] [CrossRef]
- Abdul Aziz, M.; Sabeem, M.; Mullath, S.K.; Brini, F.; Masmoudi, K. Plant Group II LEA Proteins: Intrinsically Disordered Structure for Multiple Functions in Response to Environmental Stresses. Biomolecules 2021, 11, 1662. [Google Scholar] [CrossRef]
- Liu, H.; Xing, M.; Yang, W.; Mu, X.; Wang, X.; Lu, F.; Wang, Y.; Zhang, L. Genome-wide identification of and functional insights into the late embryogenesis abundant (LEA) gene family in bread wheat (Triticum aestivum). Sci. Rep. 2019, 9, 13375. [Google Scholar] [CrossRef]
- Pan, X.X.; Hu, H.F.; Chen, N.; Zhang, H.F.; Chen, R.G. Research progress on the role of dehydrin in plant abiotic stress. J. Agric. Biotech. 2022, 30, 594–605. (In Chinese) [Google Scholar]
- Maszkowska, J.; Dębski, J.; Kulik, A.; Kistowski, M.; Bucholc, M.; Lichocka, M.; Klimecka, M.; Sztatelman, O.; Szymańska, K.P.; Dadlez, M.; et al. Phosphoproteomic analysis reveals that dehydrins ERD10 and ERD14 are phosphorylated by SNF1-related protein kinase 2.10 in response to osmotic stress. Plant Cell Environ. 2019, 42, 931–946. [Google Scholar] [CrossRef]
- Mittler, R.; Kim, Y.; Song, L.; Coutu, J.; Coutu, A.; Ciftci-Yilmaz, S.; Lee, H.; Stevenson, B.; Zhu, J.K. Gain-and loss-of-function mutations in Zat10 enhance the tolerance of plants to abiotic stress. FEBS Lett. 2006, 580, 6537–6542. [Google Scholar] [CrossRef] [PubMed]
- Brini, F.; Yamamoto, A.; Jlaiel, L.; Takeda, S.; Hobo, T.; Dinh, H.Q.; Hattori, T.; Masmoudi, K.; Hanin, M. Pleiotropic effects of the wheat dehydrin DHN-5 on stress responses in Arabidopsis. Plant Cell Physiol. 2011, 52, 676–688. [Google Scholar] [CrossRef] [PubMed]
- Xu, D.; Duan, X.; Wang, B.; Hong, B.; Ho, T.H.D.; Wu, R. Expression of a late embryogenesis abundant protein gene, HVA1, from barley confers tolerance to water deficit and salt stress in transgenic rice. Plant Physiol. 1996, 110, 249–257. [Google Scholar] [CrossRef] [PubMed]
- Houde, M.; Dallaire, S.; N’Dong, D.; Sarhan, F. Overexpression of the acidic dehydrin WCOR410 improves freezing tolerance in transgenic strawberry leaves. Plant Biotechnol. J. 2004, 2, 381–387. [Google Scholar] [CrossRef] [PubMed]
- Jing, H.; Li, C.; Ma, F.; Ma, J.H.; Khan, A.; Wang, X.; Zhao, L.Y.; Gong, Z.H.; Chen, R.G. Genome-wide identification, expression diversication of dehydrin gene family and characterization of CaDHN3 in pepper (Capsicum annuum L.). PLoS ONE 2016, 11, e0161073. [Google Scholar] [CrossRef]
- Williams, T.C.R.; Costa, M.M.D.C.; Araujo, A.C.G.; Danchin, E.G.J.; Grossi-de-Sá, M.F.; Guimaraes, P.M.; Brasileiro, A.C.M. Contrasting effects of wild Arachis dehydrin under abiotic and biotic stresses. Front. Plant Sci. 2019, 10, 497. [Google Scholar]
- Kirungu, J.N.; Magwanga, R.O.; Pu, L.; Cai, X.Y.; Xu, Y.C.; Hou, Y.Q.; Zhou, Y.; Cai, Y.F.; Hao, F.S.; Zhou, Z.L.; et al. Knockdown of Gh_A05G1554 (GhDHN_03) and Gh_D05G1729 (GhDHN_04) dehydrin genes, reveals their potential role in enhancing osmotic and salt tolerance in cotton. Genomics 2020, 112, 1902–1915. [Google Scholar] [CrossRef]
- Soliman, W.S.; Fujimori, M.; Tase, K.; Sugiyama, S. Heat tolerance and suppression of oxidative stress: Comparative analysis of 25 cultivars of the C3 grass Lolium perenne. Environ. Exp. Bot. 2012, 78, 10–17. [Google Scholar] [CrossRef]
- Ge, S.B.; Jiang, X.C.; Wang, L.Y.; Yu, J.Q.; Zhou, Y.H. Recent advances in the role and mechanism of arbuscular mycorrhizainduced improvement of abiotic stress tolerance in horticultural plan. Acta Hortic. Sin. 2020, 47, 1752–1776. (In Chinese) [Google Scholar]
- Cao, Y.; Xiang, X.; Geng, M.; You, Q.; Huang, X. Effect of HbDHN1 and HbDHN2 genes on abiotic stress responses in Arabidopsis. Front. Plant Sci. 2017, 8, 470. [Google Scholar] [CrossRef]
- Shi, H.F.; He, X.Y.; Zhao, Y.J.; Lu, S.Y.; Guo, Z.F. Constitutive expression of a group 3 LEA protein from Medicago falcata (MfLEA3) increases cold and drought tolerance in transgenic tobacco. Plant Cell Rep. 2020, 39, 851–860. [Google Scholar] [CrossRef] [PubMed]
- Li, N.; Zhao, Y.j.; Zhao, Q.; Huang, J.; Zhang, S.H. Research on barley HVA1 gene and Lea protein with plant drought tolerance. Biotechnol. Bull. 2006, 4, 25–29. (In Chinese) [Google Scholar]

| Gene Name | Gene ID | Length of CDS (bp) | Protein (aa) | Mw (Da) | PI | GRAVY |
|---|---|---|---|---|---|---|
| PmLEA1.2a | MA_185382g0010 | 252 | 83 | 9555.36 | 5.14 | −1.461 |
| PmLEA1.2b | MA_68242g0010 | 183 | 60 | 6719.4 | 4.92 | −1.187 |
| PmLEA1.2c | MA_135240g0030 | 252 | 83 | 9499.34 | 5.14 | −1.261 |
| PmLEA2 | MA_10436352g0020 | 234 | 77 | 8747.75 | 6.54 | −0.816 |
| PmLEA3.3 | MA_17049g0010 | 315 | 104 | 11,318.64 | 9.45 | −0.641 |
| PmLEA4.2a | MA_858786g0010 | 261 | 86 | 9425.61 | 9.82 | −0.834 |
| PmLEA4.2b | MA_186086g0010 | 264 | 87 | 9547.77 | 8.98 | −1.108 |
| PmLEA4.3a | MA_235g0020 | 237 | 78 | 8653.65 | 6.59 | −1.133 |
| PmLEA5 | MA_49897g0020 | 594 | 197 | 21,261.5 | 4.6 | −0.568 |
| PmLEA6 | MA_33768g0010 | 258 | 85 | 9119.17 | 8.82 | −0.906 |
| PmLEA7 | MA_487045g0010 | 279 | 92 | 10,216.44 | 9.68 | −0.636 |
| PmLEA8 | MA_40361g0020 | 258 | 85 | 9247.29 | 7.99 | −1.048 |
| PmLEA9 | MA_1400g0010 | 855 | 284 | 30,111.9 | 5.35 | −0.432 |
| PmLEA10 | MA_41069g0010 | 228 | 75 | 8480.41 | 7.11 | −1.483 |
| PmLEA11 | MA_121405g0010 | 459 | 152 | 16,652.2 | 5.47 | 0.101 |
| PmLEA12 | MA_6165882g0010 | 327 | 108 | 11,317.4 | 5.46 | −1.041 |
| PmLEA13 | MA_9339426g0010 | 444 | 147 | 15,429.68 | 8.69 | −1.3 |
| PmLEA14 | MA_10069912g0010 | 327 | 108 | 11,235.26 | 5.36 | −0.995 |
| PmLEA15 | MA_2988g0020 | 339 | 112 | 12,307.49 | 7.93 | −1.472 |
| PmLEA16 | MA_183489g0030 | 267 | 88 | 9669.63 | 6.55 | −1.097 |
| PmLEA17 | MA_10427927g0010 | 576 | 191 | 19,696.26 | 4.98 | −0.176 |
| PmLEA18 | MA_10367411g0010 | 327 | 108 | 11,221.27 | 6.22 | −0.999 |
| PmLEA19 | MA_717888g0010 | 618 | 205 | 22,872.86 | 4.07 | −0.664 |
| PmLEA20 | MA_295448g0010 | 297 | 98 | 10,065.36 | 7.88 | 0.077 |
| PmLEA21 | MA_6771381g0010 | 615 | 204 | 22,078.02 | 6.51 | −0.108 |
| PmLEA22 | MA_3108g0010 | 519 | 172 | 18,936.52 | 6.06 | −0.998 |
| PmLEA23 | MA_116141g0010 | 195 | 64 | 7691.76 | 9.46 | −1.188 |
| PmLEA24 | MA_9957327g0010 | 288 | 95 | 9578.78 | 7.78 | 0.211 |
| PmLEA25 | MA_10435107g0010 | 354 | 117 | 13,180.96 | 9.3 | −0.831 |
| PmLEA26 | MA_722400g0010 | 357 | 118 | 13,335.19 | 9.3 | −0.892 |
| PmLEA27 | MA_17597g0010 | 429 | 142 | 15,786.39 | 6.63 | −0.904 |
| PmLEA28 | MA_8427244g0010 | 504 | 167 | 17,801.05 | 6.05 | −0.086 |
| PmLEA29 | MA_432438g0020 | 420 | 139 | 15,036.16 | 9.12 | −0.347 |
| PmLEA30 | MA_21240g0010 | 300 | 99 | 10,253.2 | 6.15 | −1.004 |
| PmLEA31 | MA_111913g0010 | 2097 | 698 | 77,148.18 | 6.28 | −1.091 |
| PmLEA32 | MA_590086g0010 | 327 | 108 | 11,317.4 | 5.46 | −1.041 |
| PmLEA33 | MA_99592g0010 | 330 | 109 | 11,703.22 | 6.57 | −0.317 |
| PmLEA34 | MA_10428902g0010 | 345 | 114 | 12,130.63 | 6.82 | −0.254 |
| PmLEA35 | MA_403263g0010 | 318 | 105 | 11,438.77 | 6.27 | −0.525 |
| PmLEA36 | MA_175705g0010 | 365 | 79 | 8798.91 | 9.86 | −0.644 |
| PmLEA37 | MA_15415g0010 | 438 | 145 | 15,866.77 | 9.34 | −0.569 |
| PmLEA38 | MA_9170359g0010 | 330 | 109 | 11,878.32 | 8.05 | −0.627 |
| PmLEA39 | MA_198577g0010 | 330 | 109 | 11,836.38 | 9 | −0.483 |
| PmLEA40 | MA_90896g0010 | 333 | 110 | 11,886.34 | 9.51 | −0.501 |
| PmLEA41 | MA_132211g0010 | 294 | 97 | 10,697.91 | 6.02 | −0.427 |
| PmLEA42 | MA_42290g0010 | 306 | 101 | 10,939.48 | 6.4 | −0.372 |
| PmLEA43 | MA_326206g0010 | 474 | 157 | 16,742.6 | 5.59 | −0.693 |
| PmLEA44 | MA_4752780g0010 | 195 | 64 | 6690.4 | 8.1 | −0.87 |
| PmLEA45 | MA_41035g0010 | 680 | 190 | 20,880.29 | 9.17 | −1.168 |
Disclaimer/Publisher’s Note: The statements, opinions and data contained in all publications are solely those of the individual author(s) and contributor(s) and not of MDPI and/or the editor(s). MDPI and/or the editor(s) disclaim responsibility for any injury to people or property resulting from any ideas, methods, instructions or products referred to in the content. |
© 2024 by the authors. Licensee MDPI, Basel, Switzerland. This article is an open access article distributed under the terms and conditions of the Creative Commons Attribution (CC BY) license (https://creativecommons.org/licenses/by/4.0/).
Share and Cite
Wang, Y.; Li, J.; Bai, Y. Identification of Picea mongolica LEA Gene Family Implicates PmLEA25 in Drought Resistance. Forests 2024, 15, 1988. https://doi.org/10.3390/f15111988
Wang Y, Li J, Bai Y. Identification of Picea mongolica LEA Gene Family Implicates PmLEA25 in Drought Resistance. Forests. 2024; 15(11):1988. https://doi.org/10.3390/f15111988
Chicago/Turabian StyleWang, Yaping, Jiaqi Li, and Yu’e Bai. 2024. "Identification of Picea mongolica LEA Gene Family Implicates PmLEA25 in Drought Resistance" Forests 15, no. 11: 1988. https://doi.org/10.3390/f15111988
APA StyleWang, Y., Li, J., & Bai, Y. (2024). Identification of Picea mongolica LEA Gene Family Implicates PmLEA25 in Drought Resistance. Forests, 15(11), 1988. https://doi.org/10.3390/f15111988

